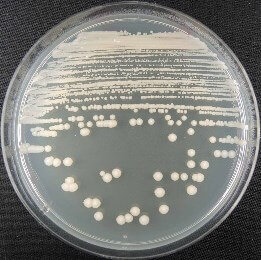

平板培養におけるコロニーの形成
平板培養におけるコロニーの形成には、菌種の違い以外に、塗抹/接種方法が大きく影響します。
試験・分析をなるべく短い時間で完了するためにも、塗抹/接種方法は重要です。
下図は、当社にお送りいただく検体の事例を示したものです。
培養による純度確認には、細菌は3日、酵母は5日、カビは7日程度の作業日数が必要となります。
純化作業が必要な場合は、コロニーの状態により、複数回の塗抹培養を繰り返す事があります。この場合、1週間~10日程度掛かることもあります。
単一コロニーが認められ、純粋性の判断が容易な例
平板内が単一種で構成され、単一のコロニーを形成していれば、そこから釣菌した再培養やDNA抽出が容易に行えます。

単一コロニーが認められるが、複数種のコロニーが混在する例
複数の菌が混在する場合においても、単一のコロニーが認められれば、ご目的のコロニーに〇印などの印を付けていただくことで、スムーズな解析が行えるケースがあります。


単一コロニーが認められない、混釈平板、液体培養物やカビの混在するなどの例
単一コロニーの形成が認められないため、培養確認または、純化作業が必要になります。 本試験の納期日とは別に、培養確認、純化作業の作業日数が必要となります。






